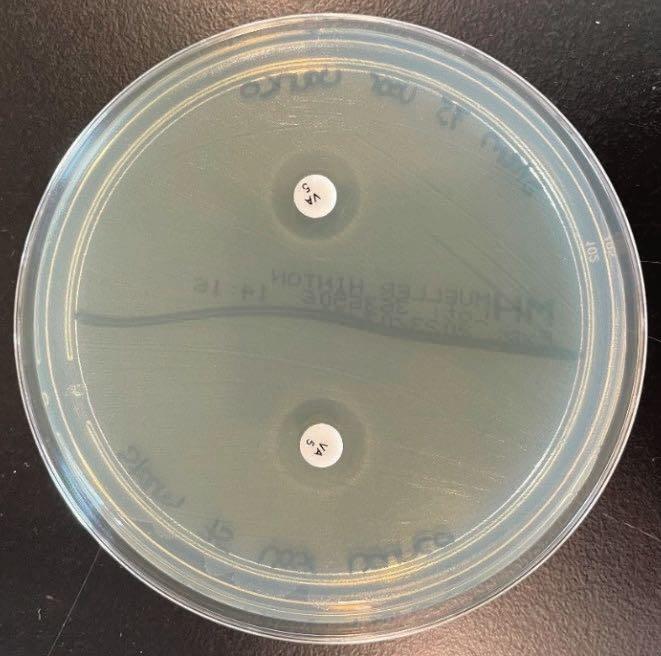
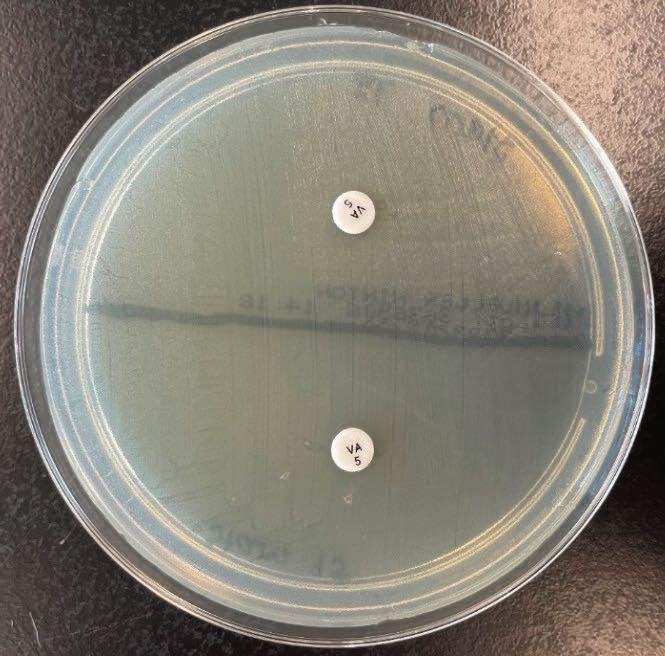

Het Vriendenfonds heeft het onderzoek naar onverwachtse resistentie van bacteriën ondersteund; in het bijzonder van-comycine-resistente enterokokken. De collega’s van Medische Microbiologie lichten het onderzoek toe.
Antibiotica resistentie in enterokokken
Antibiotica worden ingezet voor het bestrijden van bacteriële infec-ties. Wanneer antibiotica worden toegepast, zoeken bacteriën manieren om te overleven. De bacteriën doen kleine aanpassingen of nemen complete, nieuwe resistentiemechanismen op uit hun omgeving, waardoor de antibiotica niet meer werken. Bacteriën ontwikkelen op deze manier een ongevoeligheid – ook wel resisten-tie genoemd – voor antibiotica. Wanneer bacteriën resistent of ongevoelig worden voor antibiotica, kunnen infecties niet of zeer moeilijk behandeld kunnen worden.
Jacky Flipse, medisch moleculair microbioloog bij Rijnstate: “Onze studie richt zich op vancomycine-resistentie in enterokokken. Vancomycine is een antibioticum dat vaak als eerstekeusbehandeling wordt gebruikt bij infecties met enterokokken (Enterococcus faecium in het bijzonder) in longen, darmen, hersenvlies, beenmerg en hart. Vancomycine-resistentie in enterokokken beperkt de behandelopties en is een zorgwekkende ontwikkeling. In deze stu-die kijken wij naar vancomycine-variabele enterokokken (VVE). De keuze voor VVE is gebaseerd op de berichten vanuit Denemarken waar verspreiding van VVE is gezien. Deze VVE bevatten een com-pleet resistentiemechanisme voor vancomycine maar zijn niet dui-delijk meetbaar als resistente enterokokken.”
Indien een VVE een diepe infectie veroorzaakt is de infectie mogelijk levensbedreigend en wordt de patiënt langdurig behandeld met vancomycine. Dan zijn de omstandigheden ideaal voor het ont-staan van vancomycine resistentie. Voor VVE geldt dit ten zeerste: De VVE kan resistent worden onder behandeling, maar wordt in eer-ste instantie gemist omdat de bacterie vóór behandeling antibioti-ca-gevoelig lijkt. Door deze VVE in een vroeg stadium te herkennen kan de behandeling veranderd worden zodat adequaat behandeld wordt en het ontstaan van resistentie voorkomen wordt.

De grote gelijkenis tussen de Deense en Nederlandse samenleving en zorg-systemen maakt dat het Medisch Microbiologisch en Immunologisch Laboratorium (MIL) in Rijnstate een onderzoek wil doen naar deze VVE. In samenwerking met het Maastricht Universitair Medisch Centrum is er gekeken naar enterokokken uit invasieve infecties. Die zijn onderzocht met behulp van kweek en moleculaire technieken.
Resultaten
In totaal zijn er door beide laboratoria 479 kweken met enterokok-ken onderzocht. Deze kweken werden onder andere genomen uit buikvocht, bloed, urine en longvocht. In 27 van deze 479 kweken (5.6%) zijn vancomycine resistente genen aangetroffen. Achttien van deze 27 kweken waren al vancomycine resistent bij de eerste meting; negen kweken bleken mogelijk gevoelig om alsnog resis-tentie te kunnen ontwikkelen. Van deze negen kweken waren er zes beschikbaar om te kijken of deze alsnog resistentie kunnen ontwik-kelen voor vancomycine.
Na herhaaldelijke blootstelling aan een vancomycine tablet resul-teerde dit alsnog in een vancomycine resistentie bij drie van de zes kweken (zie ook foto 2A/B onderaan). De resistentie bleek samen te vallen met waargenomen veranderingen in eiwitten.
Conclusie
Vancomycine-variabele enterokokken komen voor in Nederland, maar in lage aantallen. Het is daarom niet effectief om standaard alle enterokokken te testen op aanwezigheid van vancomycine-resistentie genen. Moleculaire analyse kan overwogen worden als een Entercoccus faecium bij herhaling wordt gekweekt uit diep-ver-kregen materialen.

![Even voorstellen (Nathalie Mulder) Rijnstate 2024_1 zonder adv Image[15]](https://rijnstate.mpodemo.nl/wp-content/uploads/2024/09/Rijnstate-2024_1-zonder-adv-Image15-150x150.jpg)

